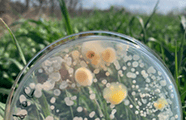

Décembre 2022
Techshow, Adequabio, Global Stim, Métropole Aix-Marseille Trophée iCapital


























Retrouvez ici toutes nos newsletters en téléchargement